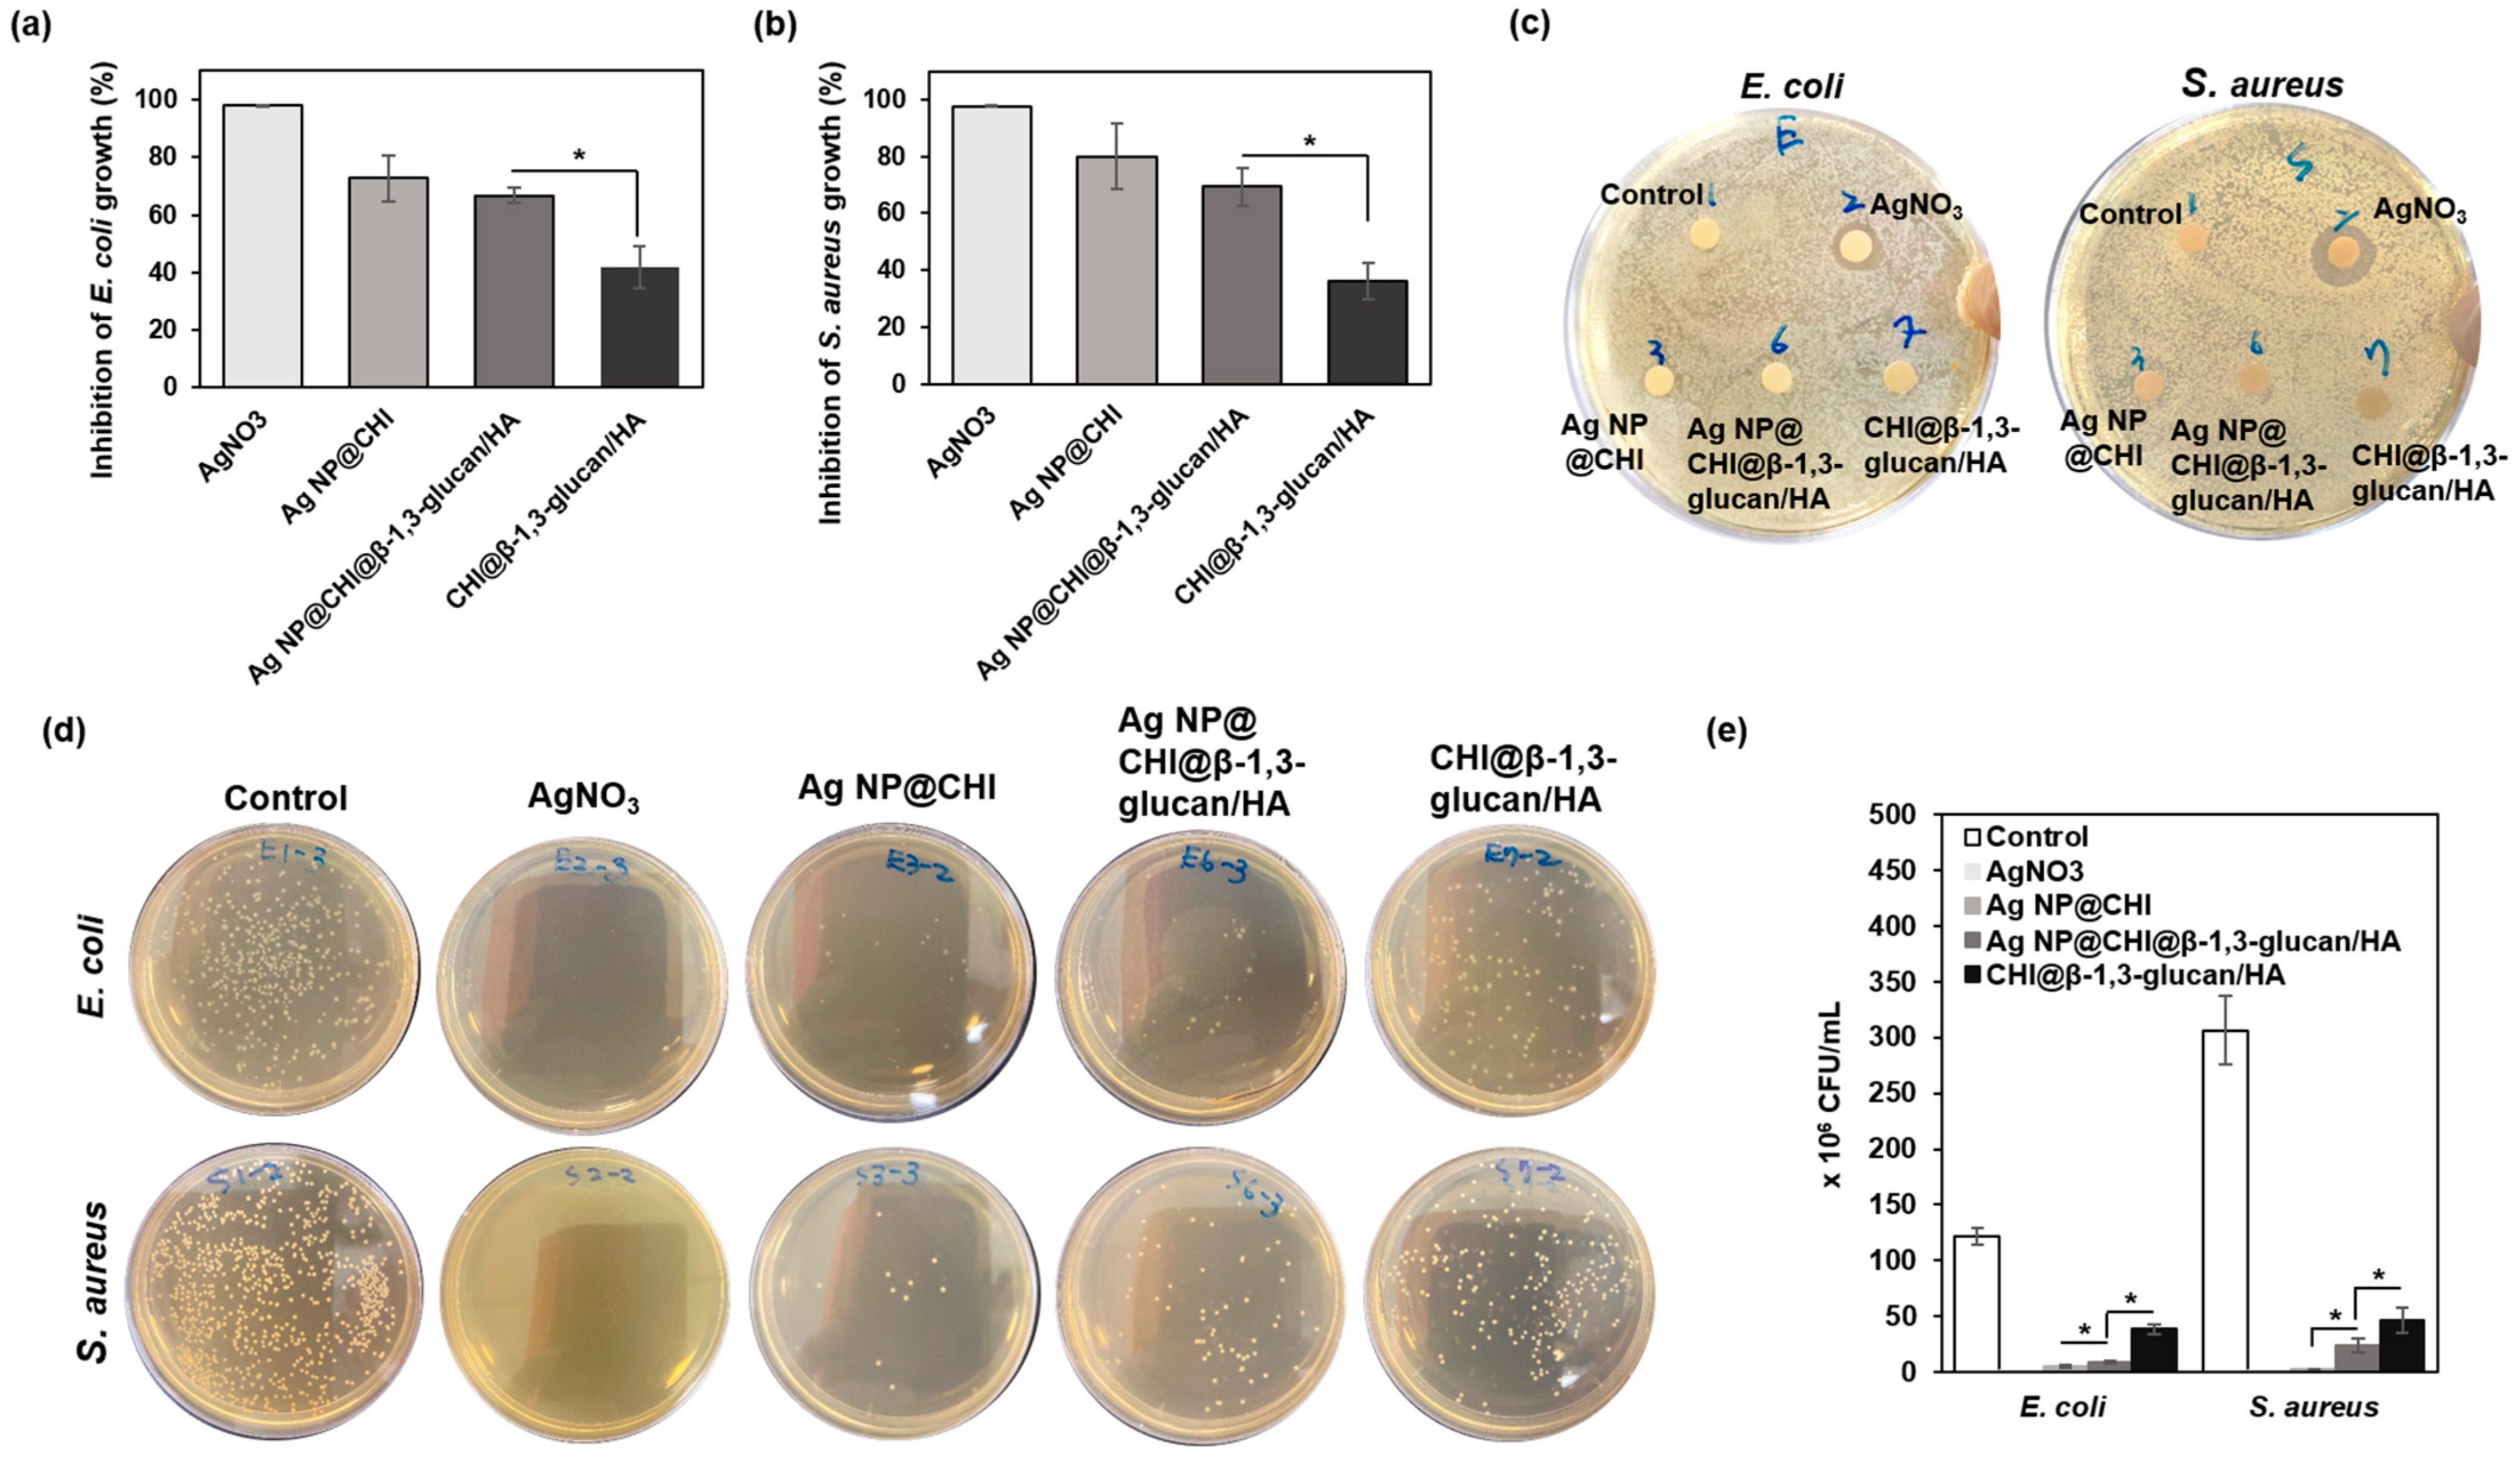
Polymers 17 00350 g007

Development of a Chitosan-Silver Nanocomposite/β-1,3-Glucan/Hyaluronic Acid Composite as an Antimicrobial System for Wound Healing
Abstract
1. Introduction
2. Materials and Methods
2.1. Materials
2.2. Preparation of Ag NP@CHI
2.3. Preparation of Ag NP@CHI@β-1,3-Glucan/HA
2.4. Characterization of Ag NP@CHI and Ag NP@CHI@β-1,3-Glucan/HA
2.5. Cytotoxicity of Ag NP@CHI and Ag NP@CHI@β-1,3-Glucan/HA
2.6. Hemocompatibility of Ag NP@CHI and Ag NP@CHI@β-1,3-Glucan/HA
2.7. Coagulation Time of Blooding (CBT) of Ag NP@CHI@β-1,3-Glucan/HA
2.8. Migration Rate Determination
2.9. In Vitro Antibacterial Activity
2.9.1. Bacterial Co-Culture Method
2.9.2. Agar Well Diffusion Method
2.9.3. Plate-Counting Method
2.10. Statistical Analysis
3. Results and Discussion
3.1. Characterization of the Ag NP@CHI
3.2. Antibacterial Activity of Ag NP@CHI
3.3. Characterization of Ag NP@CHI@β-1,3-Glucan/HA
3.4. Hemocompatibility and CBT of Ag NP@CHI and Ag NP@CHI@β-1,3-Glucan/HA
3.5. Cytotoxicity and Cell Migration Induced by Ag NP@CHI and Ag NP@CHI@β-1,3-Glucan/HA
3.6. In Vitro Antibacterial Activity of Ag NP@CHI and Ag NP@CHI@β-1,3-Glucan/HA
4. Conclusions
Author Contributions
Funding
Institutional Review Board Statement
Data Availability Statement
Acknowledgments
Conflicts of Interest
References
- Greenhalgha, R.; Dempsey-Hibbert, N.C.; Whitehead, K.A. Antimicrobial strategies to reduce polymer biomaterial infections and their economic implications and considerations. Int. Biodeterior. Biodegrad. 2019, 136, 1–14. [Google Scholar] [CrossRef]
- Das Ghatak, P.; Mathew-Steiner, S.S.; Pandey, P.; Roy, S.; Sen, C.K. A surfactant polymer dressing potentiates antimicrobial efficacy in biofilm disruption. Sci. Rep. 2018, 8, 873. [Google Scholar] [CrossRef] [PubMed]
- Mouro, C.; Dunne, C.P.; Gouveia, I.C. Designing New Antibacterial Wound Dressings: Development of a Dual Layer Cotton Material Coated with Poly(Vinyl Alcohol)_Chitosan Nanofibers Incorporating Agrimonia eupatoria L. Extract. Molecules 2020, 26, 83. [Google Scholar] [CrossRef] [PubMed]
- Ye, H.; Cheng, J.; Yu, K. In situ reduction of silver nanoparticles by gelatin to obtain porous silver nanoparticle/chitosan composites with enhanced antimicrobial and wound-healing activity. Int. J. Biol. Macromol. 2019, 121, 633–642. [Google Scholar] [CrossRef]
- Valle, K.Z.M.; Saucedo Acuña, R.A.; Ríos Arana, J.V.; Lobo, N.; Rodriguez, C.; Cuevas-Gonzalez, J.C.; Tovar-Carrillo, K.L. Natural Film Based on Pectin and Allantoin for Wound Healing: Obtaining, Characterization, and Rat Model. Biomed. Res. Int. 2020, 2020, 6897497. [Google Scholar] [CrossRef]
- Vakilian, S.; Jamshidi-Adegani, F.; Al Yahmadi, A.; Al-Broumi, M.; Ur Rehman, N.; Anwar, M.U.; Alam, K.; Al-Wahaibi, N.; Shalaby, A.; Alyaqoobi, S.; et al. A competitive nature-derived multilayered scaffold based on chitosan and alginate, for full-thickness wound healing. Carbohydr. Polym. 2021, 262, 117921. [Google Scholar] [CrossRef]
- Bahadoran, M.; Shamloo, A.; Nokoorani, Y.D. Development of a polyvinyl alcohol/sodium alginate hydrogel-based scaffold incorporating bFGF-encapsulated microspheres for accelerated wound healing. Sci. Rep. 2020, 10, 7342. [Google Scholar] [CrossRef]
- Hong, T.; Yin, J.Y.; Nie, S.P.; Xie, M.Y. Applications of infrared spectroscopy in polysaccharide structural analysis: Progress, challenge and perspective. Food Chem. X 2021, 12, 100168. [Google Scholar] [CrossRef]
- Bano, I.; Arshad, M.; Yasin, T.; Ghauri, M.A.; Younus, M. Chitosan: A potential biopolymer for wound management. Int. J. Biol. Macromol. 2017, 102, 380–383. [Google Scholar] [CrossRef]
- Wang, Q.; Liu, S.; Wang, H.; Yang, Y. In situ pore-forming alginate hydrogel beads loaded with in situ formed nano-silver and their catalytic activity. Phys. Chem. Chem. Phys. 2016, 18, 12610–12615. [Google Scholar] [CrossRef]
- Dai, X.; Zhao, Y.; Li, J.; Li, S.; Lei, R.; Chen, X.; Zhang, X.; Li, C. Thiazolium-derivative functionalized silver nanocomposites for suppressing bacterial resistance and eradicating biofilms. New J. Chem. 2018, 42, 1316–1325. [Google Scholar] [CrossRef]
- Chen, H.; Lan, G.; Ran, L.; Xiao, Y.; Yu, K.; Lu, B.; Dai, F.; Wu, D.; Lu, F. A novel wound dressing based on a Konjac glucomannan/silver nanoparticle composite sponge effectively kills bacteria and accelerates wound healing. Carbohydr. Polym. 2018, 183, 70–80. [Google Scholar] [CrossRef] [PubMed]
- Hu, M.; Li, C.; Li, X.; Zhou, M.; Sun, J.; Sheng, F.; Shi, S.; Lu, L. Zinc oxide/silver bimetallic nanoencapsulated in PVP/PCL nanofibres for improved antibacterial activity. Artif. Cells Nanomed. Biotechnol. 2018, 46, 1248–1257. [Google Scholar] [CrossRef]
- Li, Z.-W.; Li, C.W.; Wang, Q.; Shi, S.J.; Hu, M.; Zhang, Q.; Cui, H.H.; Sun, J.B.; Zhou, M.; Wu, G.L.; et al. The Cellular and Molecular Mechanisms Underlying Silver Nanoparticle/Chitosan Oligosaccharide/Poly(vinyl alcohol) Nanofiber-Mediated Wound Healing. J. Biomed. Nanotechnol. 2017, 13, 17–34. [Google Scholar] [CrossRef]
- Pérez-Díaz, M.; Alvarado-Gomez, E.; Magaña-Aquino, M.; Sánchez-Sánchez, R.; Velasquillo, C.; Gonzalez, C.; Ganem-Rondero, A.; Martínez-Castañon, G.; Zavala-Alonso, N.; Martinez-Gutierrez, F. Anti-biofilm activity of chitosan gels formulated with silver nanoparticles and their cytotoxic effect on human fibroblasts. Mater. Sci. Eng. C Mater. Biol. Appl. 2016, 60, 317–323. [Google Scholar] [CrossRef]
- Zhang, J.; Zhao, X.; Wang, Y.; Zhu, L.; Yang, L.; Li, G.; Sha, Z. Preparation and Structural Analysis of Nano-Silver Loaded Poly(styrene-co-acrylic acid) Core-Shell Nanospheres with Defined Shape and Composition. Nanomaterials 2017, 7, 234. [Google Scholar] [CrossRef]
- Choi, Y.; Ryu, G.H.; Min, S.H.; Lee, B.R.; Song, M.H.; Lee, Z.; Kim, B.S. Interface-controlled synthesis of heterodimeric silver-carbon nanoparticles derived from polysaccharides. ACS Nano 2014, 8, 11377–11385. [Google Scholar] [CrossRef]
- Xu, P.; Liang, X.; Chen, N.; Tang, J.; Shao, W.; Gao, Q.; Teng, Z. Magnetic separable chitosan microcapsules decorated with silver nanoparticles for catalytic reduction of 4-nitrophenol. J. Colloid Interface Sci. 2017, 507, 353–359. [Google Scholar] [CrossRef]
- Song, J.; Zhang, P.; Cheng, L.; Liao, Y.; Xu, B.; Bao, R.; Wang, W.; Liu, W. Nano-silver in situ hybridized collagen scaffolds for regeneration of infected full-thickness burn skin. J. Mater. Chem. B 2015, 3, 4231–4241. [Google Scholar] [CrossRef]
- Gao, Y.; Dong, Q.; Lan, S.; Cai, Q.; Simalou, O.; Zhang, S.; Gao, G.; Chokto, H.; Dong, A. Decorating CdTe QD-Embedded Mesoporous Silica Nanospheres with Ag NPs to Prevent Bacteria Invasion for Enhanced Anticounterfeit Applications. ACS Appl. Mater. Interfaces 2015, 7, 10022–10033. [Google Scholar] [CrossRef]
- Ghavami Nejad, A.; Rajan Unnithan, A.; Ramachandra Kurup Sasikala, A.; Samarikhalaj, M.; Thomas, R.G.; Jeong, Y.Y.; Nasseri, S.; Murugesan, P.; Wu, D.; Hee Park, C.; et al. Mussel-Inspired Electrospun Nanofibers Functionalized with Size-Controlled Silver Nanoparticles for Wound Dressing Application. ACS Appl. Mater. Interfaces 2015, 7, 12176–12183. [Google Scholar] [CrossRef] [PubMed]
- Phan, T.T.V.; Phan, D.T.; Cao, X.T.; Huynh, T.C.; Oh, J. Roles of Chitosan in Green Synthesis of Metal Nanoparticles for Biomedical Applications. Nanomaterials 2021, 11, 273. [Google Scholar] [CrossRef] [PubMed]
- Huang, H.; Yang, X. Synthesis of chitosan-stabilized gold nanoparticles in the absence/presence of tripolyphosphate. Biomacromolecules 2004, 5, 2340–2346. [Google Scholar] [CrossRef] [PubMed]
- Nate, Z.; Moloto, M.J.; Mubiayi, P.K.; Sibiya, P.N. Green Synthesis of Chitosan Capped Silver Nanoparticles and Their Antimicrobial Activity. MRS Adv. 2018, 3, 2505–2517. [Google Scholar] [CrossRef]
- Venkatesham, M.; Ayodhya, D.; Madhusudhan, A.; Veerababu, N.; Veerabhadram, G. A Novel Green One-Step Synthesis of Silver Nanoparticles Using Chitosan: Catalytic Activity and Antimicrobial Studies. Appl. Nanosci. 2014, 4, 113–119. [Google Scholar] [CrossRef]
- Martínez-Castañón, G.A.; Niño-Martínez, N.; Martínez-Gutierrez, F.; Martínez-Mendoza, J.R.; Ruiz, F. Synthesis and Antibacterial Activity of Silver Nanoparticles with Different Sizes. J. Nanopart. Res. 2008, 10, 1343–1348. [Google Scholar] [CrossRef]
- Bourguignon, L.Y. Matrix hyaluronan-activated CD44 signaling promotes keratinocyte activities and improves abnormal epidermal functions. Am. J. Pathol. 2014, 184, 1912–1919. [Google Scholar] [CrossRef]
- Sahana, T.G.; Rekha, P.D. Biopolymers: Applications in wound healing and skin tissue engineering. Mol. Biol. Rep. 2018, 45, 2857–2867. [Google Scholar] [CrossRef]
- Graça, M.F.P.; Miguel, S.P.; Cabral, C.S.D.; Correia, I.J. Hyaluronic acid-Based wound dressings: A review. Carbohydr. Polym. 2020, 241, 116364. [Google Scholar] [CrossRef]
- Zerbinati, N.; Esposito, C.; Cipolla, G.; Calligaro, A.; Monticelli, D.; Martina, V.; Golubovic, M.; Binic, I.; Sigova, J.; Gallo, A.L.; et al. Chemical and mechanical characterization of hyaluronic acid hydrogel cross-linked with polyethylen glycol and its use in dermatology. Dermatol. Ther. 2020, 33, e13747. [Google Scholar] [CrossRef]
- Bohn, J.A.; BeMiller, J.N. (1→3)-b-d-Glucans as biological response modifiers: A review of structure-functional activity relationships. Carbohydr. Polym. 1995, 28, 3–14. [Google Scholar] [CrossRef]
- Sherwood, E.R.; Williams, D.L.; Di Luzio, N.R. Glucan stimulates production of antitumor cytolytic/cytostatic factor(s) by macrophages. J. Biol. Response Mod. 1986, 5, 504–526. [Google Scholar] [PubMed]
- Browder, W.; Williams, D.; Pretus, H.; Olivero, G.; Enrichens, F.; Mao, P.; Franchello, A. Beneficial effect of enhanced macrophage function in the trauma patient. Ann. Surg. 1990, 211, 605–612; discussion 612–613. [Google Scholar] [PubMed]
- Pretus, H.A.; Ensley, H.E.; McNamee, R.B.; Jones, E.L.; Browder, I.W.; Williams, D.L. Isolation, physicochemical characterization and preclinical efficacy evaluation of soluble scleroglucan. J. Pharmacol. Exp. Ther. 1991, 257, 500–510. [Google Scholar]
- Williams, J.D.; Mueller, A.; Browder, W. Glucan-based macrophage stimulators. A review of their anti-infective potential. Clin. Immunother. 1996, 5, 392–399. [Google Scholar] [CrossRef]
- Jantova, S.; Bakos, D.; Birosova, L.; Matejov, P. Biological properties of a novel coladerm-beta glucan membrane.In vitro assessment using human fibroblasts. Biomed. Pap. Med. Fac. Univ. Palacky Olomouc. Czech. Repub. 2015, 159, 67–76. [Google Scholar] [CrossRef]
- Falanga, V. Growth factors and wound healing. J. Dermatol. Surg. Oncol. 1993, 19, 711–714. [Google Scholar] [CrossRef]
- Canama, G.J.C.; Delco, M.C.L.; Talandron, R.A.; Tan, N.P. Synthesis of Chitosan-Silver Nanocomposite and Its Evaluation as an Antibacterial Coating for Mobile Phone Glass Protectors. ACS Omega 2023, 8, 17699–17711. [Google Scholar] [CrossRef]
- Yang, S.J.; Pai, J.A.; Shieh, M.J.; Chen, J.L.; Chen, K.C. Cisplatin-loaded gold nanoshells mediate chemo-photothermal therapy against primary and distal lung cancers growth. Biomed. Pharmacother. 2023, 158, 114146. [Google Scholar] [CrossRef]
- Zheng, C.; Bai, Q.; Wu, W.; Han, K.; Zeng, Q.; Dong, K.; Zhang, Y.; Lu, T. Study on hemostatic effect and mechanism of starch-based nano-microporous particles. Int. J. Biol. Macromol. 2021, 179, 507–518. [Google Scholar] [CrossRef]
- Costantini, E.; Aielli, L.; Serra, F.; De Dominicis, L.; Falasca, K.; Di Giovanni, P.; Reale, M. Evaluation of Cell Migration and Cytokines Expression Changes under the Radiofrequency Electromagnetic Field on Wound Healing In Vitro Model. Int. J. Mol. Sci. 2022, 23, 2205. [Google Scholar] [CrossRef] [PubMed]
- Zhou, D.; Yang, R.; Yang, T.; Xing, M.; Luo, G. Preparation of chitin-amphipathic anion/quaternary ammonium salt ecofriendly dressing and its effect on wound healing in mice. Int. J. Nanomed. 2018, 13, 4157–4169. [Google Scholar] [CrossRef] [PubMed]
- Dou, Z.; Li, B.; Wu, L.; Qiu, T.; Wang, X.; Zhang, X.; Shen, Y.; Lu, M.; Yang, Y. Probiotic-Functionalized Silk Fibroin/Sodium Alginate Scaffolds with Endoplasmic Reticulum Stress-Relieving Properties for Promoted Scarless Wound Healing. ACS Appl. Mater. Interfaces 2023, 15, 6297–6311. [Google Scholar] [CrossRef] [PubMed]
- Zhuang, Y.; Zhang, S.; Yang, K.; Ren, L.; Dai, K. Antibacterial activity of copper-bearing 316L stainless steel for the prevention of implant-related infection. J. Biomed. Mater. Res. B Appl. Biomater. 2020, 108, 484–495. [Google Scholar] [CrossRef]
- Li, Q.; Lu, F.; Zhou, G.; Yu, K.; Lu, B.; Xiao, Y.; Dai, F.; Wu, D.; Lan, G. Silver Inlaid with Gold Nanoparticle/Chitosan Wound Dressing Enhances Antibacterial Activity and Porosity, and Promotes Wound Healing. Biomacromolecules 2017, 18, 3766–3775. [Google Scholar] [CrossRef]
- Mondal, P.; Yarger, J.L. Synthesis and Characterization of 1H-Imidazole-4,5-dicarboxylic Acid-Functionalized Silver Nanoparticles: Dual Colorimetric Sensors of Zn2+ and Homocysteine. ACS Omega 2022, 7, 33423–33431. [Google Scholar] [CrossRef]
- Parmar, A.; Kaur, G.; Kapil, S.; Sharma, V.; Choudhary, M.K.; Sharma, S. Novel biogenic silver nanoparticles as invigorated catalytic and antibacterial tool: A cleaner approach towards environmental remediation and combating bacterial invasion. Mater. Chem. Phys. 2019, 238, 121861. [Google Scholar] [CrossRef]
- Meng, Y. A Sustainable Approach to Fabricating Ag Nanoparticles/PVA Hybrid Nanofiber and Its Catalytic Activity. Nanomaterials 2015, 5, 1124–1135. [Google Scholar] [CrossRef]
- Fouad, H.; Yang, G.; El-Sayed, A.A.; Mao, G.; Khalafallah, D.; Saad, M.; Ga’al, H.; Ibrahim, E.; Mo, J. Green synthesis of AgNP-ligand complexes and their toxicological effects on Nilaparvata lugens. J. Nanobiotechnol. 2021, 19, 318. [Google Scholar] [CrossRef]
- Yin, I.X.; Zhang, J.; Zhao, I.S.; Mei, M.L.; Li, Q.; Chu, C.H. The Antibacterial Mechanism of Silver Nanoparticles and Its Application in Dentistry. Int. J. Nanomed. 2020, 15, 2555–2562. [Google Scholar] [CrossRef]
- Paomephan, P.; Assavanig, A.; Chaturongakul, S.; Cady, N.C.; Bergkvist, M.; Niamsiri, N. Insight into the antibacterial property of chitosan nanoparticles against Escherichia coli and Salmonella Typhimurium and their application as vegetable wash disinfectant. Food Control 2018, 86, 294–301. [Google Scholar] [CrossRef]
- Pan, C.; Qian, J.; Fan, J.; Guo, H.; Gou, L.; Yang, H.; Liang, C. Preparation nanoparticle by ionic cross-linked emulsified chitosan and its antibacterial activity. Colloids Surf. A 2019, 568, 362–370. [Google Scholar] [CrossRef]
- Jeon, Y.J.; Park, P.J.; Kim, S.K. Antimicrobial effect of chitooligosaccharides produced by bioreactor. Carbohyd. Polym. 2001, 44, 71–76. [Google Scholar] [CrossRef]
- No, H.K.; Park, N.Y.; Lee, S.H.; Meyers, S.P. Antibacterial activity of chitosans and chitosan oligomers with different molecular weights. Int. J. Food Microbiol. 2002, 74, 65–72. [Google Scholar] [CrossRef]
- Hosseinnejad, M.; Jafari, S.M. Evaluation of different factors affecting antimicrobial properties of chitosan. Int. J. Biol. Macromol. 2016, 85, 467–475. [Google Scholar] [CrossRef]
- Gilli, R.; Kacuráková, M.; Mathlouthi, M.; Navarini, L.; Paoletti, S. FTIR studies of sodium hyaluronate and its oligomers in the amorphous solid phase and in aqueous solution. Carbohydr. Res. 1994, 263, 315–326. [Google Scholar] [CrossRef]
- Zielke, C.; Lu, Y.; Poinsot, R.; Nilsson, L. Interaction between cereal β-glucan and proteins in solution and at interfaces. Colloids Surf. B Biointerfaces 2018, 162, 256–264. [Google Scholar] [CrossRef]
- Horkay, F.; Basser, P.J.; Londono, D.J.; Hecht, A.M.; Geissler, E. Ions in hyaluronic acid solutions. J. Chem. Phys. 2009, 131, 184902. [Google Scholar] [CrossRef]
- Denzinger, M.; Held, M.; Scheffler, H.; Haag, H.; Nussler, A.K.; Wendel, H.P.; Schlensak, C.; Daigeler, A.; Krajewski, S. Hemocompatibility of different burn wound dressings. Wound Repair Regen. 2019, 27, 470–476. [Google Scholar] [CrossRef]
- Pasaribu, K.M.; Gea, S.; Ilyas, S.; Tamrin, T.; Radecka, I. Characterization of Bacterial Cellulose-Based Wound Dressing in Different Order Impregnation of Chitosan and Collagen. Biomolecules 2020, 10, 1511. [Google Scholar] [CrossRef]
- Ohno, N.; Suzuki, T.; Saito, K.; Yadomae, T. Enhancement of clot formation of human plasma by beta-glucans. J. Pharmacobiodyn. 1990, 13, 525–532. [Google Scholar] [CrossRef] [PubMed]
- Chan, L.W.; Kim, C.H.; Wang, X.; Pun, S.H.; White, N.J.; Kim, T.H. PolySTAT-modified chitosan gauzes for improved hemostasis in external hemorrhage. Acta Biomater. 2016, 31, 178–185. [Google Scholar] [CrossRef]
- Hidalgo, E.; Domínguez, C. Study of cytotoxicity mechanisms of silver nitrate in human dermal fibroblasts. Toxicol. Lett. 1998, 98, 169–179. [Google Scholar] [CrossRef] [PubMed]
- Qing, Y.; Cheng, L.; Li, R.; Liu, G.; Zhang, Y.; Tang, X.; Wang, J.; Liu, H.; Qin, Y. Potential antibacterial mechanism of silver nanoparticles and the optimization of orthopedic implants by advanced modification technologies. Int. J. Nanomed. 2018, 13, 3311–3327. [Google Scholar] [CrossRef] [PubMed]
- Meikle, T.G.; Dyett, B.P.; Strachan, J.B.; White, J.; Drummond, C.J.; Conn, C.E. Preparation, Characterization, and Antimicrobial Activity of Cubosome Encapsulated Metal Nanocrystals. ACS Appl. Mater. Interfaces 2020, 12, 6944–6954. [Google Scholar] [CrossRef] [PubMed]
- Chapa González, C.; González García, L.I.; Burciaga Jurado, L.G.; Carrillo Castillo, A. Bactericidal activity of silver nanoparticles in drug-resistant bacteria. Braz. J. Microbiol. 2023, 54, 691–701. [Google Scholar] [CrossRef]

Disclaimer/Publisher’s Note: The statements, opinions and data contained in all publications are solely those of the individual author(s) and contributor(s) and not of MDPI and/or the editor(s). MDPI and/or the editor(s) disclaim responsibility for any injury to people or property resulting from any ideas, methods, instructions or products referred to in the content. |
© 2025 by the authors. Licensee MDPI, Basel, Switzerland. This article is an open access article distributed under the terms and conditions of the Creative Commons Attribution (CC BY) license (https://creativecommons.org/licenses/by/4.0/).
Share and Cite
Yao, C.-J.; Yang, S.-J.; Shieh, M.-J.; Young, T.-H. Development of a Chitosan-Silver Nanocomposite/β-1,3-Glucan/Hyaluronic Acid Composite as an Antimicrobial System for Wound Healing. Polymers 2025, 17, 350. https://doi.org/10.3390/polym17030350
Yao C-J, Yang S-J, Shieh M-J, Young T-H. Development of a Chitosan-Silver Nanocomposite/β-1,3-Glucan/Hyaluronic Acid Composite as an Antimicrobial System for Wound Healing. Polymers. 2025; 17(3):350. https://doi.org/10.3390/polym17030350
Chicago/Turabian StyleYao, Cheng-Jung, Shu-Jyuan Yang, Ming-Jium Shieh, and Tai-Horng Young. 2025. "Development of a Chitosan-Silver Nanocomposite/β-1,3-Glucan/Hyaluronic Acid Composite as an Antimicrobial System for Wound Healing" Polymers 17, no. 3: 350. https://doi.org/10.3390/polym17030350
APA StyleYao, C.-J., Yang, S.-J., Shieh, M.-J., & Young, T.-H. (2025). Development of a Chitosan-Silver Nanocomposite/β-1,3-Glucan/Hyaluronic Acid Composite as an Antimicrobial System for Wound Healing. Polymers, 17(3), 350. https://doi.org/10.3390/polym17030350

